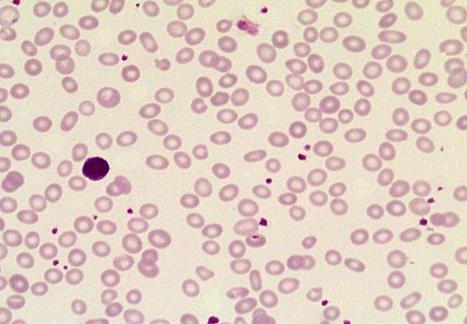

Главная страница Случайная страница
КАТЕГОРИИ:
АвтомобилиАстрономияБиологияГеографияДом и садДругие языкиДругоеИнформатикаИсторияКультураЛитератураЛогикаМатематикаМедицинаМеталлургияМеханикаОбразованиеОхрана трудаПедагогикаПолитикаПравоПсихологияРелигияРиторикаСоциологияСпортСтроительствоТехнологияТуризмФизикаФилософияФинансыХимияЧерчениеЭкологияЭкономикаЭлектроника
Профессиональная задача. 32-летняя больная, обратилась по поводу общей слабости, утомляемости, сонливости днем
|
|
32-летняя больная, обратилась по поводу общей слабости, утомляемости, сонливости днем. Ухудшение самочувствия заметила три-четыре месяца назад и связывала с эмоциональными и физическими нагрузками. Пыталась лечиться самостоятельно: принимала биодобавки, поливитамины, но состояние продолжало ухудшаться – появилась одышка, сердцебиение при физических нагрузках и она обратилась к участковому врачу.
При осмотре: состояние удовлетворительное, кожные покровы, видимые слизистые чистые, бледные, сухие, обнаружена ломкость ногтей, выпадение волос, глоссит. Пальпация грудины безболезненна. Периферические лимфоузлы не пальпируются. ЧДД 20 в 1 мин. В легких перкуторно – ясный легочный звук в симметричных участках легких, аускультативно – везикулярное дыхание, хрипы не выслушиваются. АД – 120/70 мм.рт.ст. Тоны сердца ритмичны, приглушены, выслушивается мягкий систолический шум над всеми точками аускультации. Пульс – 90 уд./мин., удовлетворительных качеств. Живот при пальпации мягкий, безболезненный, печень - по краю реберной дуги, селезенка не пальпируется. Периферических отеков нет. Мочеиспускание свободное, безболезненное. Стул, диурез – в норме. Месячные по 5 дней, обильные.
Общий анализ крови – Нв – 67 г/л, эритроциты – 3, 0х1012/л, ЦП – 0, 7, тромбоциты – 150х109/л, лейкоциты – 3, 2х109/л, СОЭ – 18 мм/ч.
ВОПРОСЫ:
Поставьте диагноз и обоснуйте его.
2.Нуждается ли больная в дообследовании и каком?
Дифференциальная диагностика с другими анемиями.
Назначьте лечение.
Оцените эффективность терапии и побочные действия препаратов.